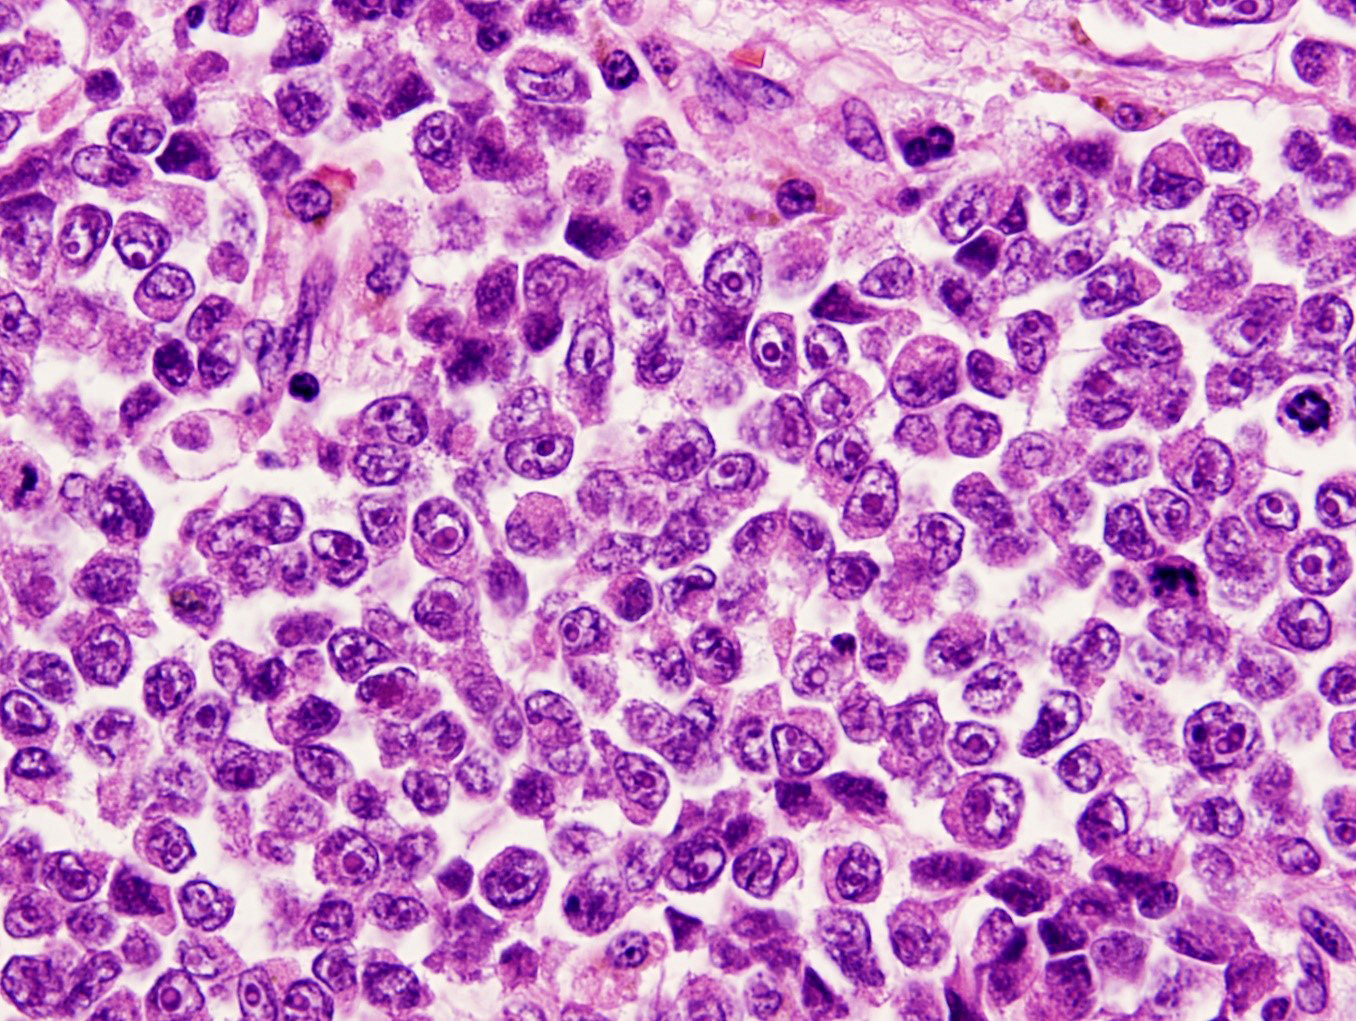

Table of Contents
Definition / general | Essential features | Terminology | ICD coding | Epidemiology | Sites | Pathophysiology | Etiology | Clinical features | Diagnosis | Radiology description | Radiology images | Prognostic factors | Case reports | Treatment | Clinical images | Gross description | Gross images | Microscopic (histologic) description | Microscopic (histologic) images | Positive stains | Negative stains | Molecular / cytogenetics description | Sample pathology report | Differential diagnosis | Practice question #1 | Practice answer #1 | Practice question #2 | Practice answer #2Cite this page: Nakanishi Y. Melanoma. PathologyOutlines.com website. https://www.pathologyoutlines.com/topic/esophagusmelanoma.html. Accessed August 21st, 2025.
Definition / general
- Primary malignant melanoma developing from the esophageal mucosa / melanocyte
Essential features
- Middle aged to elderly patients, with male predominance
- Protruding tumor with pigmentation / black discoloration in the middle or lower esophagus
- Epithelioid or spindle melanoma cells with junctional melanocytic activity / junctional melanocytic component
- Aggressive tumor
Terminology
- Primary malignant melanoma of the esophagus
ICD coding
- ICD-10: C15.9 - malignant neoplasm of the esophagus, unspecified
Epidemiology
- ~0.3 - 0.8% of all esophageal tumors (Esophagus 2021;18:1, Histopathology 2021;78:240)
- Middle aged to elderly patients, with male predominance (Mod Pathol 2019;32:957, Thorac Cancer 2019;10:950, Histopathology 2021;78:240)
Sites
- Most common in the distal third of the esophagus (Mod Pathol 2019;32:957, Dis Esophagus 2019 Oct 30 [Epub ahead of print])
- Lower esophagus (58% [44/76 cases] to 60% [12/20 cases]); middle esophagus (34% [26/76 cases] to 35% [7/20 cases]) (Thorac Cancer 2019;10:950, Medicine (Baltimore) 2020;99:e20957)
Pathophysiology
Etiology
Clinical features
- Middle aged to elderly patients, with male predominance (Mod Pathol 2019;32:957, Thorac Cancer 2019;10:950, Histopathology 2021;78:240)
- Progressive dysphagia, weight loss and chest pain (Mod Pathol 2019;32:957, Dis Esophagus 2019 Oct 30 [Epub ahead of print])
Diagnosis
- Biopsy with immunohistochemistry
Radiology description
- Bulky, polypoid intraluminal masses (Radiology 1998;209:455)
Prognostic factors
- TNM staging (Medicine (Baltimore) 2020;99:e20957)
Case reports
- 68 year old man with a 20 mm amelanotic malignant melanoma of the esophagus (Oncol Lett 2018;15:9087)
- 74 year old man with an amelanotic malignant melanoma of the esophagus treated with immunotherapy (J Surg Case Rep 2021;2021:rjab393)
- 81 year old woman with a 30 mm primary malignant melanoma treated with esophagectomy and nivolumab (J Med Case Rep 2021;15:237)
- 86 year old woman with a 58 mm amelanotic malignant melanoma of the esophagus (Surg Case Rep 2019;5:4)
Treatment
- Surgical resection
- Endoscopic resection
- Immunotherapy (PD-1 inhibitor systemic treatment) (Thorac Cancer 2019;10:950)
- Chemotherapy
- Targeted therapy
Gross description
- Protruding / polypoid lesion with pigmentation / black discoloration (Oncol Lett 2019;18:1872, Histopathology 2021;78:240, Dis Esophagus 2019 Oct 30 [Epub ahead of print])
Microscopic (histologic) description
- Mostly epithelioid tumor cells with at least focal melanin pigment (Mod Pathol 2019;32:957)
- Associated melanoma in situ component (junctional melanocytic activity / junctional melanocytic component / tumor nests at the epithelium - lamina propria junction / horizontal tumor spread in the basal layer of the epithelium) and melanocytosis / melanosis (Mod Pathol 2019;32:957, Ann Thorac Surg 2013;96:1002)
Microscopic (histologic) images
Positive stains
- Melanoma markers (S100, HMB45, MelanA / MART1, MITF, SOX10, tyrosinase)
Negative stains
- Cytokeratin (mostly negative; however, anomalous cytokeratin expression has been reported) (Mod Pathol 1990;3:494, J Cutan Pathol 2021;48:1246, Am J Dermatopathol 2019;41:502)
- Squamous cell markers (p40 and p63)
- Neuroendocrine markers (chromogranin and synaptophysin); neuroendocrine markers can be expressed in malignant melanomas / malignant melanomas with neuroendocrine differentiation have been reported (Histopathology 2005;47:402)
- CD45
- CD68
Molecular / cytogenetics description
- Contrary to cutaneous melanoma, no (0% [0/22]) or few (up to 6.6%) BRAF mutations identified (Mod Pathol 2019;32:957, Thorac Cancer 2019;10:950, Virchows Arch 2009;454:513)
- NRAS mutations: 33 - 35% (Mod Pathol 2019;32:957, Virchows Arch 2009;454:513)
- Relatively common KIT mutations (10 - 50%) by next generation sequencing (NGS) analysis (Histopathology 2021;78:240 Mod Pathol 2019;32:957)
- NGS analysis revealed NF1 (30%), SF3B1 (20%), KRAS (10%), BRCA2 (10%), KIT (10%) and TP53 (10%) mutations; no BRAF mutations were detected (Histopathology 2021;78:240)
Sample pathology report
- Esophagus, mass, biopsy:
- Malignant melanoma (see comment)
- Comment: The infiltrating epithelioid tumor cells are positive for S100, HMB45, MelanA and negative for AE1 / AE3, CAM5.2, synaptophysin and chromogranin. The morphology and immunoprofile are consistent with malignant melanoma.
Differential diagnosis
- Poorly differentiated squamous cell carcinoma or adenocarcinoma:
- Keratin positive and melanoma marker negative
- Neuroendocrine carcinoma (small cell neuroendocrine carcinoma and large cell neuroendocrine carcinoma):
- Keratin positive; neuroendocrine marker positive and melanoma marker negative
- Basaloid squamous carcinoma:
- Keratin positive and melanoma marker negative
Practice question #1
Which of the following is true about primary malignant melanoma of the esophagus?
- Junctional melanocytic activity suggests a primary malignant melanoma of the esophagus
- Melanin pigments should be always found in the tumor cells by definition
- No melanocytes are found in the normal esophagus
- SOX10 is a useful marker to differentiate benign nevi from malignant melanomas
Practice answer #1
A. Junctional melanocytic activity (shown in the picture) suggests a primary malignant melanoma of the esophagus
Comment Here
Reference: Esophageal melanoma
Comment Here
Reference: Esophageal melanoma
Practice question #2
Which of the following is true about primary malignant melanoma of the esophagus?
- BRAF mutation is the most common mutation, as in cutaneous melanoma
- Cervical esophagus is the most common site
- Most cases show protruding lesions
- Smoking and alcohol consumption are important risk factors
- Usually seen in young female patients
Practice answer #2